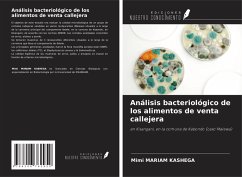

Análisis farmacológico de los aceites esenciales de hoja de cúrcuma
Un estudio in silico
Versandkostenfrei!
Versandfertig in 1-2 Wochen

PAYBACK Punkte
13 °P sammeln!



Anagha AK e Aghila T são estudantes de pós-graduação do Departamento de Zoologia do Colégio de São José (Autónomo), Devagiri, Calicute, Kerala. O Dr. Arunaksharan Narayanankutty é professor assistente no Departamento de Zoologia da PG e Investigação, St. Joseph's College (Autónomo), Devagiri, Calicute, Kerala, Índia.
Produktdetails
- Verlag: Ediciones Nuestro Conocimiento
- Seitenzahl: 60
- Erscheinungstermin: 13. Mai 2023
- Spanisch
- Abmessung: 220mm x 150mm x 4mm
- Gewicht: 107g
- ISBN-13: 9786205991558
- ISBN-10: 6205991551
- Artikelnr.: 68031924
Herstellerkennzeichnung
Die Herstellerinformationen sind derzeit nicht verfügbar.
Für dieses Produkt wurde noch keine Bewertung abgegeben. Wir würden uns sehr freuen, wenn du die erste Bewertung schreibst!
Eine Bewertung schreiben
Eine Bewertung schreiben
Andere Kunden interessierten sich für